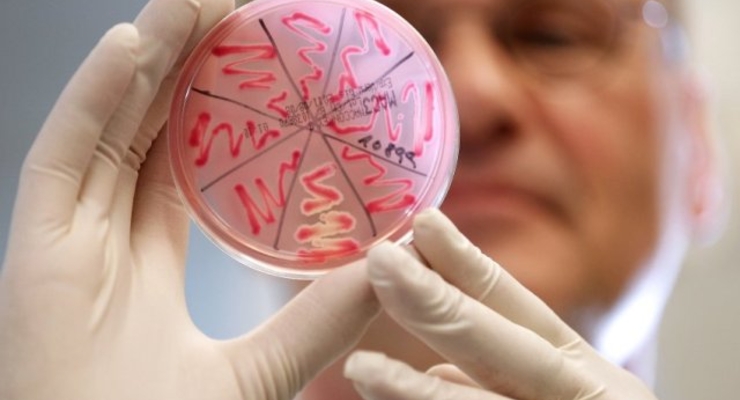
Бактерию E.coli нашли в чешской воде

Государственная сельскохозяйственная и продовольственная инспекция Чехии обнаружила опасную бактерию E.coli в бутылках с водой Aquila Aqualinea, сообщает Чешское радио.
Государственные инспекторы распорядились немедленно изъять зараженную воду из магазинов, а также обязали производителя воды проинформировать потребителей о сложившейся ситуации.
"Государственная сельскохозяйственная и продовольственная инспекция нашла при контроле бутылок негазированной воды Aquila Aqualinea бактерию E.coli", - сказал Чешскому радио пресс-секретарь инспекции Михал Спачил.
Компания-производитель воды Karlovarske mineralni vody изъяла из оборота 33 тысячи бутылок и попросила покупателей проверить уже купленную минеральную воду - на бутылке указан срок годности "до 20.05.2012".
Государственная сельскохозяйственная и продовольственная инспекция Чехии рекомендует не пить воду из этой партии.
Напомним, в Европе от кишечной инфекции, вызванной бактерией E.coli, уже погибли более 50 человек.
Изначально вспышка была зафиксирована на севере Германии.
В начале июня специалисты Европейского центра по контролю и профилактике заболеваний (ECDC) сообщили, что причиной заболеваний является редкий штамм E.сoli, принадлежащий к серотипу (вариативности внутри подвидов бактерий или вирусов) 0104: H4. Мутировавший штамм ранее не был известен, он устойчив ко многим антибиотикам.
В четверг специалисты ECDC заявили, что зараженные бактерией E.coli семена могли быть ввезены в Европу из Египта в 2009-2010 годах. Эта информация позднее была опровергнута египетским министерством сельского хозяйства.
Ранее сообщалось о том, что источник заражения являются пророщенные бобы.
По материалам РИА Новости







